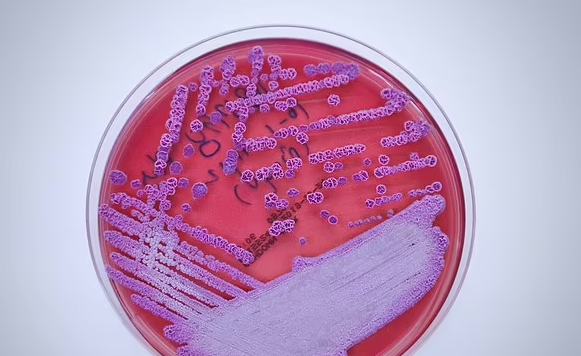
txt

اختلطت مياه جزر فارو بـ الدم ، بعد أن ذبح بوحشية 100 من الدلافين قارورية الأنف، ليثير ذلك استياء وغضب الكثيرين المهتمين بـ البيئة على مستوى دولي، حيث استخدم الصيادون آلات حادة لـ تسرع من عملية قتل الدلافين، وذلك ضمن فاعليات مهرجان سنوي في جزر فارو.
قام سكان الجزيرة بـ رعاية الدلافين حيث مكثوا لعدة ساعات ، قبل أن يتم ذبحهم، حيث انتظر الرجال في المياه الضحلة لقتل الحيوانات بخطافات وسكاكين ورماح ، مما جعل الخليج أحمر اللون.
مع تسليط الضوء بالفعل على المنطقة لمطاردة الحيتان السنوية ، أدانت جماعات حقوق الحيوان هذه الممارسة باعتبارها بربرية، بحسب ما نشرت صحيفة "ديلي ستار" البريطانية.
ومع ذلك جادل السكان بأنه جزء مهم من تقاليدهم المحلية، وفقًا لكبار صيادي الحيتان في الجزيرة ، كانت هذه هي المرة الأولى التي يستخدم فيها الصيادون رمحًا مصممًا لتسريع وقت القتل وتقليل معاناتهم.
يدحض الخبراء النظريات القائلة بأن رمح القتل يجعل العملية أكثر إنسانية، وقالت أستريد فوكس ، مديرة السياسات في منظمة Whales and Dolphin Conservation: "تعتبر الدلافين ذات الأنف القارورة من أكثر أنواع الدلافين المحبوبة والتي تمت دراستها جيدًا".
وأضافت: "إن قتل 100 من هؤلاء الدلافين هو إشارة سياسية لإظهار للعالم أن صيادي الدلافين في جزر فارو لا يهتمون برأي شعوبهم أو آراء المجتمع الدولي".
فيما أكدت :"يحدونا أمل كبير في أن تستجيب المملكة المتحدة والاتحاد الأوروبي لهذا الموقف بالضغوط الدبلوماسية والاقتصادية اللازمة"، وحصلت عريضة مؤخرًا على 1.3 مليون توقيع من جميع أنحاء العالم تدعو إلى وقف صيد الدلافين على الفور.
يدعي مركز WDC أن استطلاعًا للرأي بين سكان جزر فارو أظهر أن غالبية السكان يشعرون بأن الصيد يجب أن ينتهي، هذا لأن لحم الدلفين قاروري الأنف ليس مطلوبًا بشدة ، ولا تندرج الأنواع ضمن حوت الطيار التقليدي، حيث يتم ذبح الأنواع الأخيرة بالمثل على طول خلجان الجزر.
في العام الماضي ، أظهرت الصور المروعة لأكبر مذبحة دولفين مسجلة في جزر فارو جثثًا تلطخ الشواطئ والبحر مصبوغًا بدمائهم باللون الأحمر.
يقال إن الصيادين قد قتلوا 1428 من الحيوانات خلال أسبوع واحد في يونيو من العام الماضي ؛ أكبر حصيلة قتلى مسجلة على الإطلاق من الصيد السنوي التقليدي منذ قرن من الزمان.
يُعرف المهرجان الرهيب باسم grindadráp أو 'grind' ، والذي يعود تاريخه إلى عصر الفايكنج، ووفقًا للبيانات التي تحتفظ بها جزر فارو ، وهي شبه مستقلة وجزء من المملكة الدنماركية ، يتم قتل ما يصل إلى 1000 من الثدييات البحرية كل عام خلال هذا الحدث.